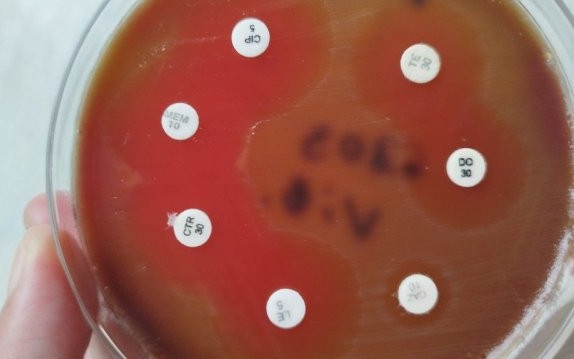

В разгара на горещините, когато температурите се задържат трайно високи, мнозина допускат грешки, които могат да застрашат здравето им. Кардиологът проф. Арман Постаджиян разкри кои са най-честите грешки, които допускаме в жегите и отговори на въпросите защо бирата на плажа е опасна и кога трябва да се коригира терапията за кръвно. Според проф. Постаджиян, продължителната гореща вълна дава възможност на организма да се адаптира, за разлика от резките температурни промени, които са по-голям стрес за тялото. "Най-голям е пикът на проблеми, когато има по-рязка промяна в рамките на няколко дни“, уточни той.Рисковете за кръвното наляганеКардиологът обясни, че зимата е по-опасният сезон за хората с високо кръвно, тъй като студът предизвиква свиване на кръвоносните съдове. През лятото се случва обратното – съдовете се разширяват (дилатация), което води до понижаване на кръвното налягане, пише NOVA."Обичайно летният период върви с по-малко проблеми с високото кръвно налягане, отколкото зимата“, каза проф. Постаджиян. Именно затова основният риск в жегите е свързан с прекалено ниски стойности на кръвното, особено при хора на терапия.Най-честите грешки и съвети към хипертоницитеНай-голямата грешка, която пациентите с хипертония допускат, е самоволно да спират или намаляват лекарствата си. "Ако сте бил на три медикамента, изведнъж да спрете и трите, защото може 3-5 дни нищо да не ви стане, но след това физиологията ще започне отново да дава своето“, предупреди специалистът.Той беше категоричен:Следете кръвното си налягане: Всеки човек на терапия трябва редовно да проверява стойностите си.Консултирайте се с лекар: Ако забележите трайно отклонение от обичайните си стойности, задължително се консултирайте с лекуващия си лекар. Само той може да прецени дали е нужна корекция на терапията.Внимание с диуретиците: Хората, които приемат лекарства за обезводняване (диуретици), особено тези със сърдечна недостатъчност, трябва да бъдат изключително внимателни, тъй като в жегите рискът от дехидратация е много по-висок.Хидратация и храненеОсновният съвет на проф. Постаджиян за справяне с горещините е приемът на много течности."Течности, течности и още течности. Хапчето е това“, заяви той. Според него е препоръчително да се приемат над два литра на ден, като организмът сам подсказва от какво има нужда. Интересен съвет, който даде, е да се предпочитат по-хладки или дори леко затоплени напитки (като чай) пред леденостудените, тъй като те помагат за по-доброто разхлаждане.Алкохолът, включително и бирата, е силно непрепоръчителен. "Алкохолът всъщност е проблемен, заради факта, че допълнително извлича течности. Тоест, той ни дехидратира още повече“, подчерта кардиологът.По отношение на храната, той посъветва да се придържаме към по-леки менюта, богати на плодове, зеленчуци и салати, и да се избягват тежки и мазни храни.